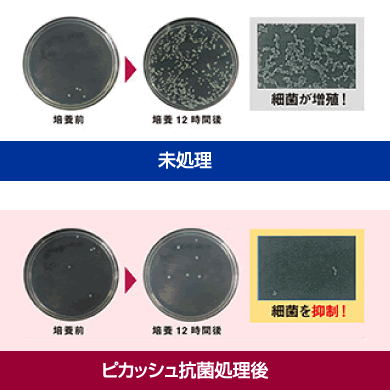

ピカッシュとは?
ブランカ歯科では、入れ歯の気になる臭いの除去・細菌の付着に抗菌コーティング「ピカッシュ」を導入しています。
抗菌コーティングでニオイの元から予防する

- 入れ歯の匂いが気になる方に
- お口を清潔に保ちたい方のために
新品でもご使用中の物でも、あっという間にAG+(銀イオン)を抗菌コーティングします。
銀イオンによる除菌洗浄で口臭を予防
入れ歯の無数の小さな傷についた汚れや雑菌は、通常の洗浄で取り切れません。
ピカッシュは、銀イオン(Ag+)コーティングで、これらの傷がつきにくく、雑菌も汚れも溜まりにくくしてしてくれます。
そもそも、装置自体にニオイと雑菌を付きにくくするのです。
ピカッシュの抗菌効果
一度塗布すると数ヶ月以上もの間、継続的な効果が期待できます。
一度塗布すると数ヶ月以上もの間、継続的な効果が期待できます。
その効果は、第三者機関でも証明されており、市販の洗浄剤や、磨くという従来のお手入れ法だけでは落としきれなかった入れ歯ニオイやヨゴレも付きにくくなるため、水洗いなどの簡単なケアで済みます。
安全性と持続性に優れているため、口の中に入れたままでも安心です。





